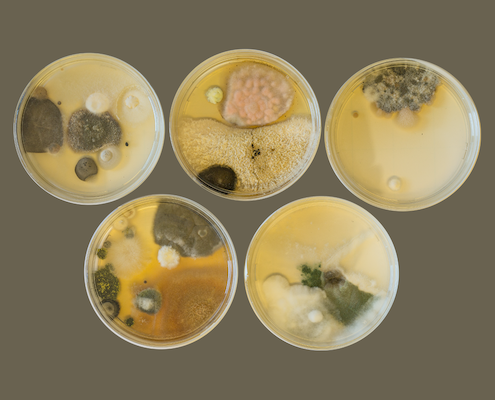

Electric, magnetic and electromagnetic fields (EMF)
Indoor electrosmog
Electric, magnetic or electromagnetic fields (EMF) are colloquially referred to as electrosmog (e-smog) and describes the sum of existing electric or magnetic fields as well as electromagnetic radiation and their possible interactions the effects on humans.
Electric or magnetic fields are generated e.g. by the A/C 230V (50Hz) power supply in electrical installations, numerous electrical household appliances, lighting, office equipment, computers or consumer electronics as well as by railroad current (16.7 Hz). In Germany, electromagnetic fields include e.g. DVB+/DVB-T, W-LAN, Bluetooth, Tetra or mobile radio services such as GSM, UMTS, LTE, 5G.
WLAN or Bluetooth has arrived today in almost every office or household up to the children’s rooms their application can be found in numerous devices such as smartphones, tablets, laptops, computers, smart home or home entertainment. The sum of the possible sources can influence the well-being or health. Due to the permanent influence of electromagnetic fields, negative health effects can occur in people. This can lead from single symptoms to complex diseases such as headaches / migraines, chronic fatigue, loss of performance, nervousness, sleep disorders, weakening of the immune system.
In recent years, an increase in electro-hypersensitive people has been registered. (Electro-hypersensitivity EHS). EHS has been classified as a multi-system disease by the European Academy of Environmental Medicine (EUROPAEM). Many sleeping places often have too high values of technical fields from a building biology point of view . Effects of electrosmog are usually the sum of many sources that affect the organism. For particularly sensitive areas such as the sleeping place, according to the recommendations of building biology, at best there should be no EMF fields or, if possible, only very low EMF fields.